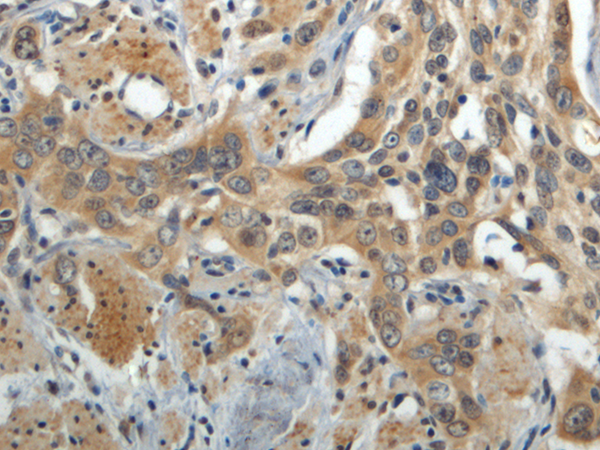
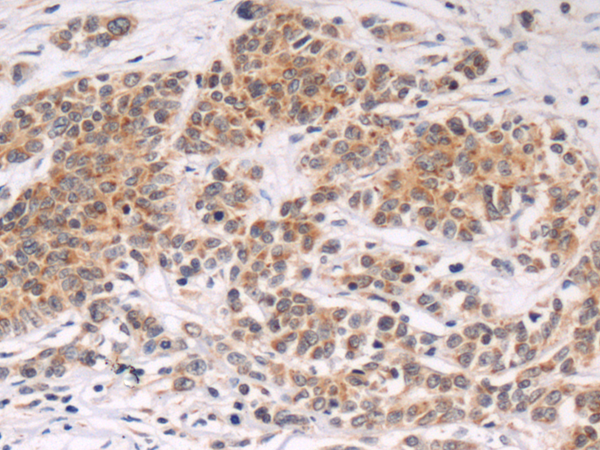
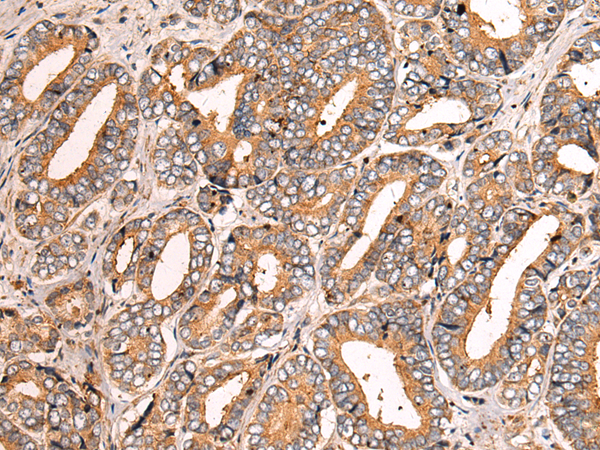
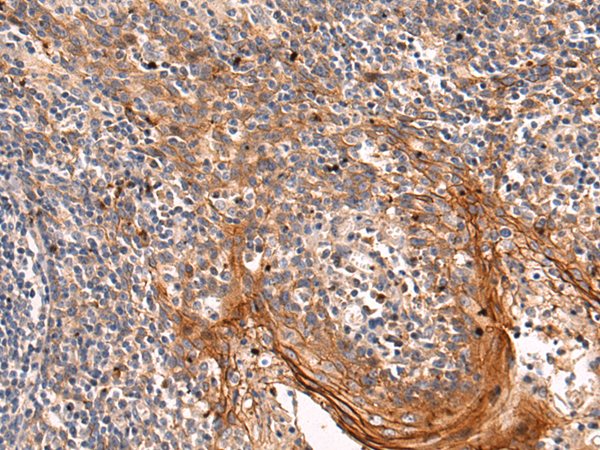

-
分类: 科研抗体货号: P10494别名: CBG; GLUC; KLRP; CBGL1应用: WB,IHC反应种属: Human
-
分类: 科研抗体货号: P10511别名: CPL应用: IHC反应种属: Human, Mouse, Rat
-
分类: 科研抗体货号: P10509别名: FUK; 1110046B12Rik应用: IHC反应种属: Human, Mouse
-
分类: 科研抗体货号: P10524别名: RD; SC; BTN5; PRO2801应用: IHC反应种属: Human, Mouse
-
分类: 科研抗体货号: P10537别名: A-SCS; A-BETA; MTDPS5; LINC00444; SCS-betaA应用: WB,IHC反应种属: Human, Mouse
-
分类: 科研抗体货号: P10523别名: TAKRP; TA-KRP应用: WB,IHC反应种属: Human, Mouse, Rat
-
分类: 科研抗体货号: P10536别名: P78; MCRS2; MSP58; INO80Q; ICP22BP应用: WB,IHC反应种属: Human, Mouse
-
分类: 科研抗体货号: P10522别名: DNA2L; hDNA2应用: IHC反应种属: Human
-
分类: 科研抗体货号: P10535别名: BAP; MSS; ULG5应用: WB,IHC反应种属: Human, Mouse, Rat
-
分类: 科研抗体货号: P10521别名: DIA; POF; DIA2; DRF2; POF2; POF2A应用: IHC反应种属: Human, Mouse

鄂公网安备42018502007531号
鄂公网安备42018502007531号

